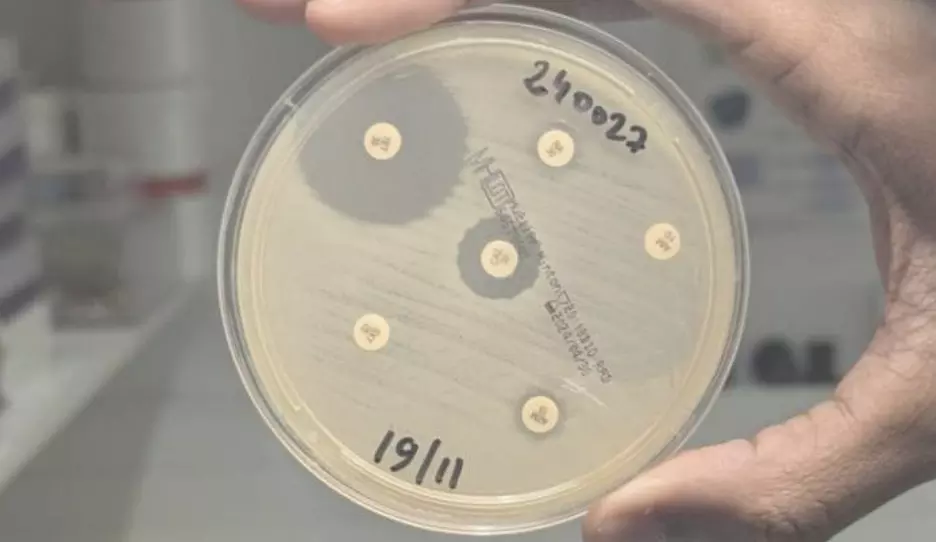

Highly drug-resistant Cholera strain spreads from Yemen to France
Highly drug-resistant Cholera strain spreads from Yemen to France
A groundbreaking study by scientists from the National Reference Center for Vibrios and Cholera at the Institut Pasteur, in partnership with the Center hospitalier de Mayotte, has revealed the alarming spread of a highly drug-resistant cholera strain. Published on December 11, 2024, in the New England Journal of Medicine, the research highlights the potential threat this strain poses to global health.
Cholera, a severe diarrheal disease caused by the Vibrio cholerae bacterium, can be deadly within hours without proper treatment. While rehydration therapy is crucial, antibiotics play a vital role in reducing infection duration and halting transmission. However, the strain identified in this study is resistant to 10 antibiotics, including azithromycin and ciprofloxacin, two key drugs used to treat the disease.
The first appearance of this resistant strain was documented during the 2018-2019 cholera outbreak in Yemen. Since then, it has spread across the globe, reaching Lebanon in 2022, Kenya in 2023, and most recently, Tanzania, the Comoros Islands, and Mayotte—an island off the coast of France—in 2024. Between March and July of this year, Mayotte experienced an outbreak with 221 reported cases linked to this highly resistant strain.
This research underscores the urgent need for enhanced global surveillance of cholera and the continuous monitoring of bacterial resistance. Professor François-Xavier Weill, Head of the Vibrios CNR at the Institut Pasteur and lead author of the study, emphasized the potential danger: “If the new strain circulating acquires resistance to tetracycline, it could jeopardize all current oral antibiotic treatments.”
The study serves as a critical reminder of the evolving nature of infectious diseases and the importance of proactive measures to combat antibiotic resistance.

